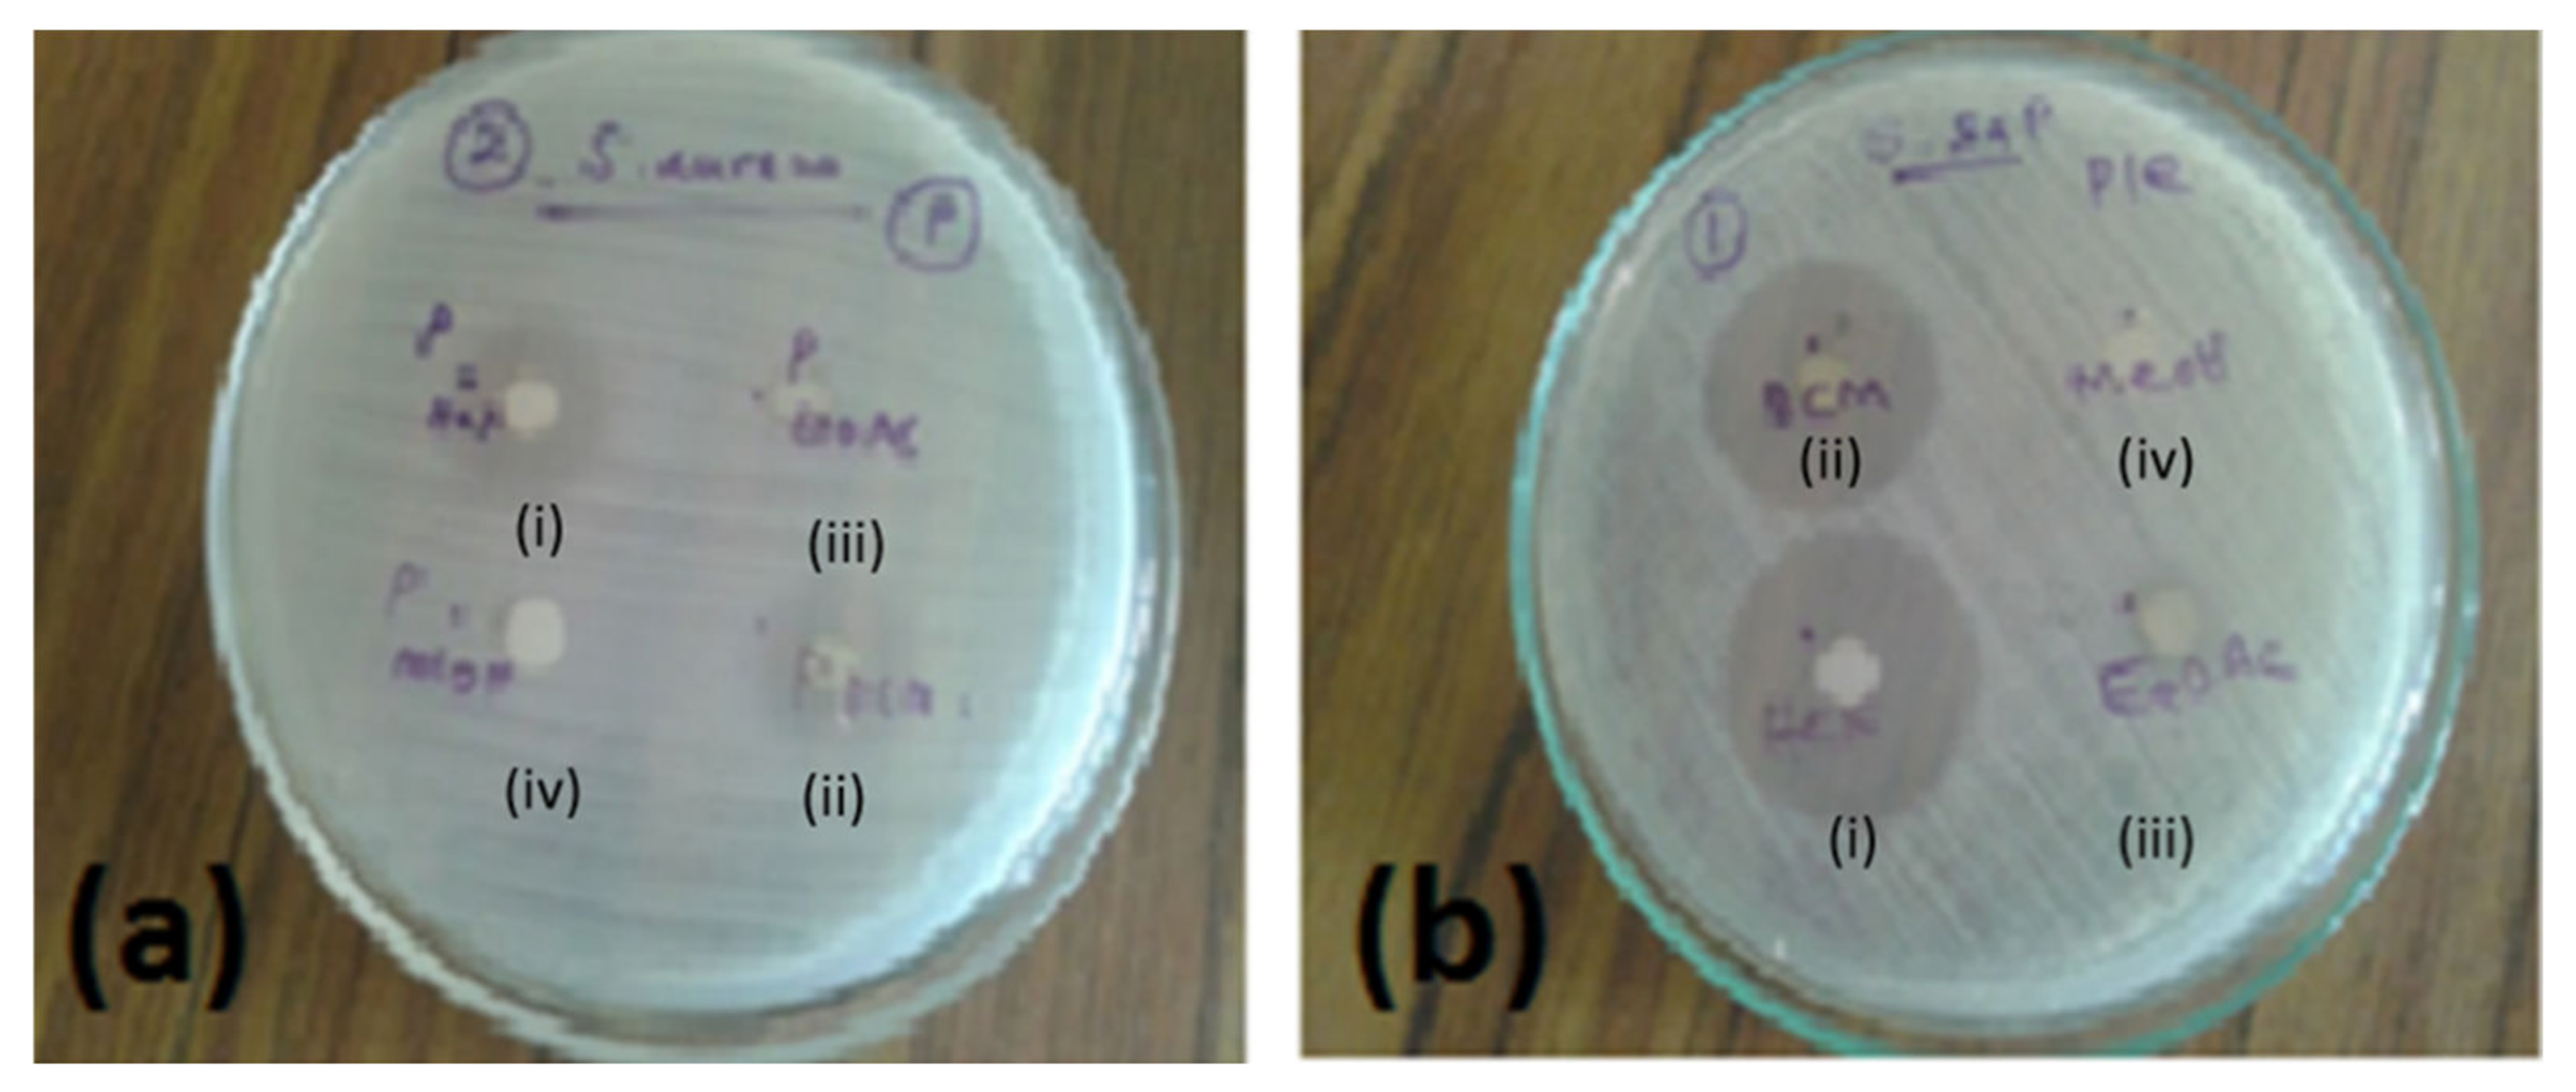
Pharmaceuticals 15 00436 g001

Plectranthus zeylanicus: A Rich Source of Secondary Metabolites with Antimicrobial, Disinfectant and Anti-Inflammatory Activities
Abstract
:1. Introduction
2. Results
2.1. Antimicrobial Activity of the Crude Extracts of P. zeylanicus
2.2. Phytochemical Screening by Gas Chromatography-Coupled Mass Spectrometric (GC-MS) Analysis
2.3. Bioactivity-Guided Fractionation
2.4. Bioactivity Studies of the Isolated Compound
2.4.1. Antimicrobial Activity and Disinfectant Potency
2.4.2. Anti-Inflammatory Activity
3. Discussion
4. Materials and Methods
4.1. Plant Material
4.2. Preparation of Crude Extracts
4.3. Evaluation of Antimicrobial Activity for Bioactivity-Guided Fractionation
4.3.1. Pre-Screening of Crude Extracts for Antibacterial Activity
4.3.2. Determination of Minimum Inhibitory Concentration
4.4. Phytochemical Profiling and Bioactivity-Guided Fractionation of Most Active Extract
4.4.1. Phytochemical Profiling by GC-MS Analysis
4.4.2. Bioactivity-Guided Fractionation
4.5. Evaluation of the Bioactivity of Pure Compound
4.5.1. Antimicrobial Activity
Antibacterial Activity
Anti-Candida Activity
Disinfectant Potency
4.5.2. Anti-Inflammatory Activity
Cell-Free 5-LO Activity Assay
Cell-Based 5-LO Activity Assay
Statistical Analysis
5. Conclusions
Author Contributions
Funding
Institutional Review Board Statement
Informed Consent Statement
Data Availability Statement
Acknowledgments
Conflicts of Interest
Appendix A
| No. | This Paper | Bernardes et al. [15] | ||
|---|---|---|---|---|
| 1H NMR | 13C NMR | 1H NMR | 13C NMR | |
| δ, mult., J (Hz) | δ | δ | δ | |
| 1β | 2.63, ddd, 12.8/6.6/3.4 | 39.2 | 2.62 | 38.37 |
| 1α | 1.19, overlap | ~1.17 | ||
| 2α | 1.53, ddd, 13.8/7.0/3.6 | 19.8 | 1.55 | 19.70 |
| 2β | 1.86, ddd, 13.8/7.3/3.6 | 1.83 | ||
| 3α | 1.23, m | 43.2 | ~1.20 | 42.28 |
| 3β | 1.44, m | 1.46 | ||
| 4 | 34.4 | 33.67 | ||
| 5α | 1.36, brs, 2.7 fwhm | 50.6 | 1.32 | 49.76 |
| 6α | 4.25, brs, 5.0 fwhm | 67.0 | 4.31 | 67.00 |
| 7β | 5.64, dd, 2.2/0.6 | 69.4 | 5.65 | 68.75 |
| 8 | 137.9 | 137.12 | ||
| 9 | 150.8 | 149.91 | ||
| 10 | 39.6 | 38.63 | ||
| 11 | 184.2 | 183.29 | ||
| 12 | 153.4 | 150.90 | ||
| 13 | 124.9 | 124.69 | ||
| 14 | 186.9 | 185.74 | ||
| 15 | 3.17, sept | 24.9 | 3.14 | 24.17 |
| 16 | 1.17, d, 7.1 | 20.1 | 1.17 * | 19.84 |
| 17 | 1.19, d, 7.1 | 20.3 | 1.20 * | 19.70 |
| 18 | 0.93, s | 34.0 | 0.93 | 33.52 |
| 19 | 1.24, s | 24.1 | 1.21 | 23.81 |
| 20 | 1.64, s | 21.9 | 1.59 | 21.51 |
| 7α-Ac-Me | 1.95, s | 20.9 | 2.02 | 20.93 |
| 7α-Ac-CO | 169.5 | 169.60 | ||
References
- Dassanayake, M.D.; Fosberg, F.R. A Revised Handbook to the Flora of Ceylon, 1st ed.; Amerind Publ. Co., Ltd.: New Delhi, India, 1981; Volume 3, pp. 150–151. [Google Scholar]
- Napagoda, M.; Gerstmeier, J.; Wesely, S.; Popella, S.; Lorenz, S.; Scheubert, K.; Svatoš, A.; Werz, O. Inhibition of 5-lipoxygenase as anti-inflammatory mode of action of Plectranthus zeylanicus Benth and chemical characterization of ingredients by a mass spectrometric approach. J. Ethnopharmacol. 2014, 151, 800–809. [Google Scholar] [CrossRef]
- Chiang, N.; Fredman, G.; Bäckhed, F.; Oh, S.F.; Vickery, T.; Schmidt, B.A.; Serhan, C.N. Infection regulates pro-resolving mediators that lower antibiotic requirements. Nature 2012, 484, 524–528. [Google Scholar] [CrossRef] [Green Version]
- Serhan, C.N. Novel pro-resolving lipid mediators in inflammation are leads for resolution physiology. Nature 2014, 510, 92–101. [Google Scholar] [CrossRef] [PubMed] [Green Version]
- Koeberle, A.; Werz, O. Natural products as inhibitors of prostaglandin E2 and pro-inflammatory 5-lipoxygenase-derived lipid mediator biosynthesis. Biotechnol. Adv. 2018, 36, 1709–1723. [Google Scholar] [CrossRef] [PubMed]
- Jayaweera, D.M.A. Medicinal Plants (Indigenous and Exotic) Used in Ceylon, Part 2, 1st ed.; National Science Council: Colombo, Sri Lanka, 1982; pp. 108–109. [Google Scholar]
- Deena, M.J.; Sreeranjini, K.; Thoppi, J.E. Antimicrobial screening of essential oils of Coleus aromaticus and Coleus zeylanicus. Int. J. Aromather. 2002, 12, 105–107. [Google Scholar] [CrossRef]
- Kotagiri, D.; Beebi, S.K.; Chaitanya, K.V. Secondary metabolites and the antimicrobial potential of five different Coleus species in response to salinity stress. BioRxiv 2017, 220368. [Google Scholar] [CrossRef] [Green Version]
- Mehrotra, R.; Vishwakarma, R.A.; Thakur, R.S. Abietane diterpenoides from Coleus zeylanicus. Phytochemistry 1989, 28, 3135–3137. [Google Scholar] [CrossRef]
- Arambewela, L.; Wijesinghe, A. Sri Lankan Medicinal Plant Monographs and Analysis—Vol-11 Plectranthus zeylanicus, 1st ed.; National Science Foundation: Colombo, Sri Lanka, 2006. [Google Scholar]
- Jirovetz, L.; Jirovetz, K.; Buchbauer, G.; Fleischhacker, W.; Shafi, P.M.; Saidutty, A. Analyses of the essential oil of the leaves of the medicinal plant Coleus zeylanicus from India. Sci. Pharm. 1998, 66, 223–229. [Google Scholar]
- Hensch, M.; Rüedi, P.; Eugster, C.H. Horminon, Taxochinon und weitere Royleanone aus 2 abessinischen Plectranthus-Spezies (Labiatae). Helv. Chim. Acta 1975, 58, 1921–1934. [Google Scholar] [CrossRef]
- Rüedi, P. 8α,9α-Epoxy-7-oxoroyleanon, ein Diterpen-Epoxychinon aus einer abessinischen Plectranthus-Art (Labiatae). Helv. Chim. Acta 1984, 67, 1116–1120. [Google Scholar] [CrossRef]
- Teixeira, A.P.; Batista, O.; Simoes, M.F.; Nascimento, J.; Duarte, A.; de la Torre, M.C.; Rodriguez, B. Abietane diterpenoids from Plectranthus grandidentatus. Phytochemistry 1997, 44, 325–327. [Google Scholar] [CrossRef] [Green Version]
- Bernardes, C.E.S.; Garcia, C.; Pereira, F.; Mota, J.; Pereira, P.; Cebola, M.J.; Reis, C.P.; Correia, I.; Piedade, M.F.M.; da Piedade, M.E.M.; et al. Extraction optimization and structural and thermal characterization of the antimicrobial abietane 7α-acetoxy-6β-hydroxyroyleanone. Mol. Pharm. 2018, 15, 1412–1419. [Google Scholar] [CrossRef]
- O’Neill, J. Tackling Drug-Resistant Infections Globally: Final Report and Recommendations—The Review on Antimicrobial Resistance Chaired by Jim O’Neill, Wellcome Trust; HM Government: London, UK, 2016. [Google Scholar]
- Turner, N.A.; Sharma-Kuinkel, B.K.; Maskarinec, S.A.; Eichenberger, E.M.; Shah, P.P.; Carugati, M.; Holland, T.L.; Fowler, V.G., Jr. Methicillin-resistant Staphylococcus aureus: An overview of basic and clinical research. Nat. Rev. Microbiol. 2019, 17, 203–218. [Google Scholar] [CrossRef]
- Anand, U.; Jacobo-Herrera, N.; Altemimi, A.; Lakhssassi, N. A comprehensive review on medicinal plants as antimicrobial therapeutics: Potential avenues of biocompatible drug discovery. Metabolites 2019, 9, 258. [Google Scholar] [CrossRef] [PubMed] [Green Version]
- Cowan, M.M. Plant products as antimicrobial agents. Clin. Microbiol. Rev. 1999, 12, 564–582. [Google Scholar] [CrossRef] [Green Version]
- Chandra, H.; Bishnoi, P.; Yadav, A.; Patni, B.; Mishra, A.P.; Nautiyal, A.R. Antimicrobial resistance and the alternative resources with special emphasis on plant-based antimicrobials-A review. Plants 2017, 6, 16. [Google Scholar] [CrossRef]
- Rijo, P.; Esteves, M.; Simões, M.F.; Silva, A.; Duarte, A.; Rodriguez, B. Antimicrobial activity of 7α-acetoxy-6β-hydroxyroyleanone 12-O-benzoyl esters. Planta Med. 2008, 74, PB81. [Google Scholar] [CrossRef]
- Pereira, F.; Figueiredo, T.; de Almeida, R.; Antunes, C.; Garcia, C.; Reis, C.P.; Ascensão, L.; Sobral, R.G.; Rijo, P. Unveiling the mechanism of action of 7α-acetoxy-6β-hydroxyroyleanone on an MRSA/VISA strain: Membrane and cell wall interactions. Biomolecules 2020, 10, 983. [Google Scholar] [CrossRef]
- Boswihi, S.S.; Udo, E.E. Methicillin-resistant Staphylococcus aureus: An update on the epidemiology, treatment options and infection control. CMRP 2018, 8, 18–24. [Google Scholar] [CrossRef]
- Fonseka, D.L.C.K.; Wickramaarachchi, W.W.U.I.; Situge, C.D. Mass production of Plectranthus zeylanicus—A valuable medicinal and aromatic plant with a future value. IJMFM & AP 2019, 5, 15–20. [Google Scholar]
- Gertsch, E.J.; Leonti, M.; Raduner, S.; Racz, I.; Chen, J.Z.; Xie, X.Q.; Altmann, K.H.; Karsak, M.; Zimmer, A. α-caryophyllene is a dietary cannabinoid. Proc. Natl. Acad. Sci. USA 2008, 105, 9099–9104. [Google Scholar] [CrossRef] [PubMed] [Green Version]
- Fernandes, E.S.; Passos, G.F.; Medeiros, R.; da Cunha, F.M.; Ferreira, J.; Campos, M.M.; Pianowski, L.F.; Calixto, J.B. Anti-inflammatory effects of compounds α-humulene and (−)-trans-caryophyllene isolated from the essential oil of Cordia verbenacea. Eur. J. Pharmacol. 2007, 569, 228–236. [Google Scholar] [CrossRef] [PubMed]
- Goetzl, J.E. Vitamin E modulates the lipoxygenation of arachidonic acid in leukocytes. Nature 1980, 288, 183–185. [Google Scholar] [CrossRef] [PubMed]
- Kweifio-Okai, G.; Macrides, T.A. Antilipoxygenase activity of amyrin triterpenes. Res. Commun. Chem. Pathol. Pharmacol. 1992, 78, 367–372. [Google Scholar] [PubMed]
- Werz, O. Inhibition of 5-lipoxygenase product synthesis by natural compounds of plant origin. Planta Med. 2007, 73, 1331–1357. [Google Scholar] [CrossRef] [Green Version]
- Napagoda, M.; Gerstmeier, J.; Butschek, H.; Lorenz, S.; Kanatiwela, D.; De Soyza, S.D.; Qader, M.; Nagahawatte, A.; Wijayaratne, G.B.; Svatoš, A.; et al. Lipophilic extract of Leucas zeylanica, a multi-purpose medicinal plant in the tropics, inhibits key enzymes involved in inflammation and gout. J. Ethnopharmacol. 2018, 224, 474–481. [Google Scholar] [CrossRef]
- Napagoda, M.; Gerstmeier, J.; Butschek, H.; De Soyza, S.; Pace, S.; Lorenz, S.; Qader, M.; Witharana, S.; Nagahawatte, A.; Wijayaratne, G.; et al. The anti-inflammatory and antimicrobial potential of selected ethnomedicinal plants from Sri Lanka. Molecules 2020, 25, 1894. [Google Scholar] [CrossRef]
- Fischer, L.; Szellas, D.; Radmark, O.; Steinhilber, D.; Werz, O. Phosphorylation- and stimulus-dependent inhibition of cellular 5-lipoxygenase activity by nonredox-type inhibitors. FASEB J. 2003, 17, 949–951. [Google Scholar] [CrossRef]
- Steinhilber, D.; Herrmann, T.; Roth, H.J. Separation of lipoxins and leukotrienes from human granulocytes by high-performance liquid chromatography with a Radial-Pak cartridge after extraction with an octadecyl reversed-phase column. J. Chromatogr. 1989, 493, 361–366. [Google Scholar] [CrossRef]

| Extract | MIC (μg/mL) | ||||||
|---|---|---|---|---|---|---|---|
| S. aureus | S. saprophyticus | E. feacalis | S. typhi | P. aeruginosa | E. coli | S. flexneri | |
| n-hexane | 31.25 | 31.25 | 62.5 | 500 | - | - | - |
| DCM | 31.25 | 31.25 | 125 | 500 | 250 | - | - |
| ethyl acetate | 250 | 500 | - | 1000 | - | - | - |
| methanol | 500 | 500 | 250 | 1000 | - | - | - |
| Gentamicin (reference drug) | 7.5 | 7.5 | 31.25 | 3.72 | 3.72 | 7.5 | 31.25 |
| Retention Time (min) | Compound |
|---|---|
| 6.24 | a monoterpene acetate |
| 6.96 | β-caryophyllene |
| 7.05 | α-caryophyllene |
| 7.30 | γ-selinene |
| 7.39 | valencene |
| 7.61 | 7-epi-α-selinene |
| 8.23 | viridiflorol |
| 8.76 | globulol |
| 8.89 | α-bisabolol |
| 10.10 | neophytadiene |
| 10.51 | (3,7,11,15)-tetramethyl-2-hexadecen-1-ol |
| 11.29 | hexadecanoic acid |
| 13.28 | 9,12-octadecadienoic acid |
| 13.35 | 9,12,15-octadecatrienoic acid |
| 13.60 | octadecanoic acid |
| 14.31 | phytolacetate |
| 16.31 | stigmasta-5,24(28)-dien-3-ol |
| 17.46 | a compound with the formulae of C20–23HxO2–4 |
| 20.83 | heptacosane |
| 22.58 | squalene |
| 26.57 | α-tocopherol |
| 28.16 | stigmasterol |
| 28.87 | sitosterol |
| 29.81 | amyrin |
| Fraction (F)/ Sub-Fraction (SF) (No.) | Diameter of the Zone of Growth Inhibition (mm) of | |
|---|---|---|
| S. aureus | S. saprophyticus | |
| F-1 | - | 6 ± 0 |
| F-2 | - | 10 ± 0 |
| F-3 | - | - |
| F-4 | - | - |
| F-5 | 18 ± 0 | 29 ± 0 |
| F-6 | 19 ± 0 | 28 ± 0 |
| F-7 | 10 ± 0 | 15 ± 0 |
| F-8 | 7 ± 0 | 8 ± 0 |
| F-9 | - | 6 ± 0 |
| F-10 | - | - |
| F-11 | - | - |
| SF-1 | - | - |
| SF-2 | 10 ± 0 | 19 ± 0 |
| SF-3 | 22 ± 0 | 33 ± 0 |
| SF-4 | - | - |
| SF-5 | - | - |
| gentamicin (reference drug) | 16 ± 0 | 22 ± 0 |
| Comparison of Mean Colony Counts of Different Microorganisms on Different Surfaces | ||||||||||||
|---|---|---|---|---|---|---|---|---|---|---|---|---|
| P. aeruginosa | S. aureus | MRSA | ||||||||||
| Smooth Surface | Rough Surface | Smooth Surface | Rough Surface | Smooth Surface | Rough Surface | |||||||
| ANOVA Test Result | p = 0.021 | p = 0.001 | p = 0.001 | p = 0.001 | p = 0.000 | p = 0.000 | ||||||
| Mean Colony Count | Post Hoc Test vs. Untreated | Mean Colony Count | Post Hoc Test vs. Untreated | Mean Colony Count | Post Hoc Test vs. Untreated | Mean Colony Count | Post Hoc Test vs. Untreated | Mean Colony Count | Post Hoc Test vs. Untreated | Mean Colony Count | Post Hoc Test vs. Untreated | |
| Untreated surface | 5.75 | 7.5 | 45.25 | 10.75 | 487.5 | 450.0 | ||||||
| Commercial disinfectant | 1.5 | p = 0.017 | 1.5 | p = 0.001 | 0.5 | p = 0.001 | 1.0 | p = 0.001 | 5.0 | p = 0.000 | 1.25 | p = 0.000 |
| Isolated compound | 1.5 | p = 0.017 | 1.0 | p = 0.001 | 1.0 | p = 0.001 | 1.0 | p = 0.001 | 0.25 | p = 0.000 | 6.25 | p = 0.000 |
Publisher’s Note: MDPI stays neutral with regard to jurisdictional claims in published maps and institutional affiliations. |
© 2022 by the authors. Licensee MDPI, Basel, Switzerland. This article is an open access article distributed under the terms and conditions of the Creative Commons Attribution (CC BY) license (https://creativecommons.org/licenses/by/4.0/).
Share and Cite
Napagoda, M.; Gerstmeier, J.; Butschek, H.; Lorenz, S.; De Soyza, S.; Qader, M.; Nagahawatte, A.; Wijayaratne, G.B.; Schneider, B.; Svatoš, A.; et al. Plectranthus zeylanicus: A Rich Source of Secondary Metabolites with Antimicrobial, Disinfectant and Anti-Inflammatory Activities. Pharmaceuticals 2022, 15, 436. https://doi.org/10.3390/ph15040436
Napagoda M, Gerstmeier J, Butschek H, Lorenz S, De Soyza S, Qader M, Nagahawatte A, Wijayaratne GB, Schneider B, Svatoš A, et al. Plectranthus zeylanicus: A Rich Source of Secondary Metabolites with Antimicrobial, Disinfectant and Anti-Inflammatory Activities. Pharmaceuticals. 2022; 15(4):436. https://doi.org/10.3390/ph15040436
Chicago/Turabian StyleNapagoda, Mayuri, Jana Gerstmeier, Hannah Butschek, Sybille Lorenz, Sudhara De Soyza, Mallique Qader, Ajith Nagahawatte, Gaya Bandara Wijayaratne, Bernd Schneider, Aleš Svatoš, and et al. 2022. "Plectranthus zeylanicus: A Rich Source of Secondary Metabolites with Antimicrobial, Disinfectant and Anti-Inflammatory Activities" Pharmaceuticals 15, no. 4: 436. https://doi.org/10.3390/ph15040436
APA StyleNapagoda, M., Gerstmeier, J., Butschek, H., Lorenz, S., De Soyza, S., Qader, M., Nagahawatte, A., Wijayaratne, G. B., Schneider, B., Svatoš, A., Jayasinghe, L., Koeberle, A., & Werz, O. (2022). Plectranthus zeylanicus: A Rich Source of Secondary Metabolites with Antimicrobial, Disinfectant and Anti-Inflammatory Activities. Pharmaceuticals, 15(4), 436. https://doi.org/10.3390/ph15040436

